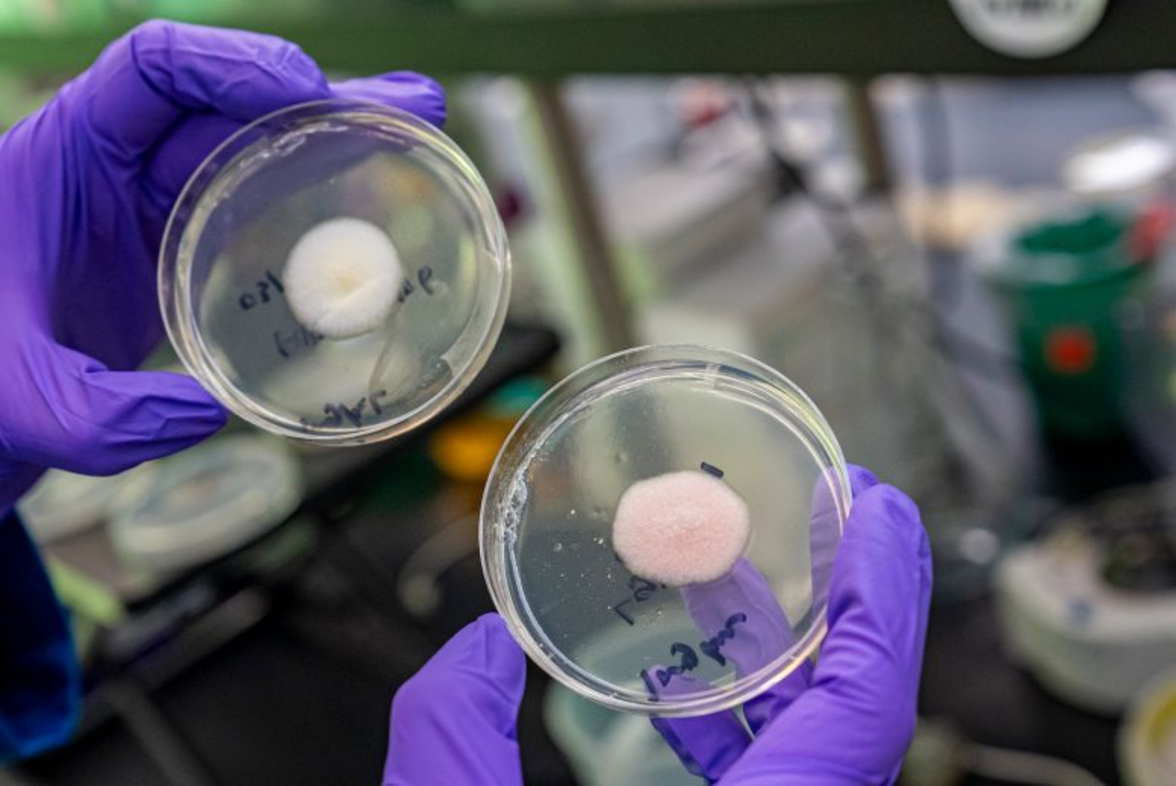

Когда на рынке уже появились не содержащие животных белков молочные продукты и хорошие вегетарианские заменители мяса, легко понять, как биотехнологии могут изменить пищевую промышленность.
Достижения генной инженерии позволяют нам использовать микроорганизмы для производства продуктов не содержащих животных компонентов, полезных для здоровья потребителей и окружающей среды. Одним из самых перспективных источников инновационных продуктов питания являются грибки - разнообразное царство организмов, которые в естественных условиях производят огромное количество вкусных и питательных белков, жиров, антиоксидантов и вкусовых молекул. Шеф-повар, ставший биоинженером, Ваю Хилл-Майни, сотрудник отдела биологических наук Калифорнийского университета, изучает многочисленные возможности получения новых вкусов и текстур за счет модификации генов, уже присутствующих в грибках.
Чашка Петри слева содержит натуральную плесень коджи, в то время как в чашке справа было сконструировано более высокое содержание питательного вещества под названием эрготионеин и больше гема - молекулы железа, которая содержится во многих организмах, но особенно много ее в тканях животных, что придает мясу характерный вкус. Фото: Marilyn Sargent/Berkeley Lab.
"Я думаю, что это фундаментальный аспект синтетической биологии, когда мы пользуемся преимуществами организмов, которые эволюционировали, чтобы быть действительно хорошими в определенных вещах", - говорит Хилл-Майни. "Мы пытаемся понять, что именно производит этот грибок, и попытаться разблокировать и улучшить это. И я думаю, что это важный момент: нам не нужно внедрять гены из совершенно разных видов. Мы изучаем, как мы можем сшивать вещи вместе и раскрывать то, что уже есть".
В своей последней работе, недавно опубликованной в журнале Nature Communications, Хилл-Майни и его коллеги изучали грибок Aspergillus oryzae, также известный как плесень коджи (кодзи), которую в Восточной Азии веками использовали для ферментации крахмала в саке, соевом соусе и мисо. Сначала исследователи использовали CRISPR-Cas9 для создания системы редактирования генов, способной вносить последовательные и воспроизводимые изменения в геном плесени коджи. После того как они создали набор инструментов для редактирования, они применили свою систему для внесения изменений, которые повышают ценность плесени как источника пищи.
Сначала Хилл-Майни сосредоточился на увеличении производства гема - молекулы железа, которая содержится во многих живых организмах, но наиболее распространена в тканях животных, придавая мясу цвет и характерный вкус. (Синтетически полученный растительный гем также придает "не мясному" бургеру его мясные свойства). Затем группа увеличила производство эрготионеина - антиоксиданта, который можно найти только в грибках и который ассоциируется с полезными для сердечно-сосудистой системы свойствами. После этих изменений некогда белые грибки стали красными. При минимальной подготовке - удалении лишней воды и измельчении - собранные грибки можно было сформировать в лепешку, а затем обжарить в виде соблазнительно выглядящего бургера.
Следующая цель Хилла-Майни - сделать грибки еще более привлекательными, настроив гены, контролирующие текстуру плесени. "Мы думаем, что есть много возможностей для изучения текстуры, изменяя морфологию клеток, похожих на волокна. Так, мы могли бы запрограммировать структуру волокон, чтобы они были длиннее, что дало бы больше сходства с мясом. А затем мы можем подумать о повышении липидного состава для создания приятного ощущения во рту", - рассказал он. "Меня очень интересует, как мы можем дальше изучать этот грибок и изменять его структуру и метаболизм для получения пищи".
Хотя эта работа - только начало пути к использованию геномов грибков для создания новых продуктов питания, она демонстрирует огромный потенциал этих организмов в качестве простых в выращивании источников белка, позволяющих избежать сложных списков ингредиентов нынешних заменителей мяса, а также ценовых барьеров и технических трудностей, препятствующих внедрению культивированного мяса. Кроме того, разработанный командой набор технологий редактирования генов - это огромный шаг вперед для синтетической биологии в целом.
В настоящее время огромное количество биопродуктов производится с помощью инженерных бактерий и дрожжей, одноклеточных родственников грибков и плесени. Однако, несмотря на долгую историю одомашнивания грибков для непосредственного употребления в пищу или приготовления основных продуктов питания, таких как мисо, многоклеточные грибки еще не использовались в качестве фабрик по производству клеток в той же степени, поскольку их геномы гораздо сложнее и имеют адаптации, которые делают редактирование генов сложной задачей. Инструментарий CRISPR-Cas9, разработанный в данном исследовании, закладывает основу для легкого редактирования плесени коджи и ее многочисленных родственников.
"Эти организмы веками использовались для производства продуктов питания, и они невероятно эффективно преобразуют углерод в широкий спектр сложных молекул, включая многие, которые практически невозможно получить с помощью классических хозяев, таких как пивные дрожжи или кишечная палочка", - говорит Хилл-Майни. ""Раскрывая" плесень коджи с помощью этих инструментов, мы обнаруживаем потенциал огромной новой группы хозяев, которые мы можем использовать для производства продуктов питания, ценных химических веществ, энергоемкого биотоплива и лекарственных препаратов. Это захватывающее новое направление для биопроизводства".
Учитывая свое кулинарное образование, Хилл-Майни стремится к тому, чтобы следующее поколение продуктов на основе грибков было не только приятным на вкус, но и по-настоящему желанным для покупателей, в том числе с утонченным вкусом. В рамках отдельного исследования он сотрудничал с шеф-поварами ресторана Alchemist в Копенгагене, отмеченного двумя звездами Мишлен, чтобы изучить кулинарный потенциал другого многоклеточного грибка, Neurospora intermedia. Этот грибок традиционно используется в Индонезии для производства основного продукта питания под названием "онком" путем ферментации отходов, оставшихся после изготовления других продуктов, таких как тофу. Заинтригованные его способностью превращать остатки пищи в богатый белком продукт, ученые и шеф-повара изучили этот грибок на экспериментальной кухне Alchemist.
Они обнаружили, что N. intermedia производит и выделяет множество ферментов в процессе роста. При выращивании на крахмалистом рисе грибок вырабатывает фермент, который разжижает рис и делает его очень сладким. "Мы разработали процесс, в котором всего из трех ингредиентов - риса, воды и грибка - получалась красивая, поразительного оранжевого цвета каша", - рассказывает Хилл-Майни. "Это стало новым блюдом в дегустационном меню и я думаю, что это действительно показывает, что существует возможность соединить лабораторию и кухню".
